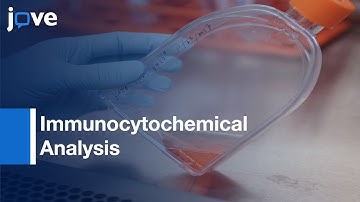

⬇ DOWNLOAD NOW
Kalau muncul iklan pop-up, tutup lalu klik tombol kembali
Download lagu Neural Stem Cells Induction from Peripheral Blood HSCs | Protocol Preview secara gratis hanya untuk keperluan promosi. Dukung artis favorit kamu dengan membeli musik original di iTunes atau platform resmi lainnya.
 Neural Stem Cells (NSCs) Injection in conditions of Chronic EAE | Protocol Preview
Neural Stem Cells (NSCs) Injection in conditions of Chronic EAE | Protocol Preview
 Blood-Derived Neuronal Cells (GM-Free) Generation | Protocol Preview
Blood-Derived Neuronal Cells (GM-Free) Generation | Protocol Preview
Neural Stem Cells infection for Immunocytochemical Analysis | Protocol Preview
Neural Stem Cells infection for Immunocytochemical Analysis | Protocol Preview
 Hemogenic Endothelium and Blood Induction by Overexpression of TF | Protocol Preview
Hemogenic Endothelium and Blood Induction by Overexpression of TF | Protocol Preview
 Induction of hematopoietic stem cells in zebrafish
Induction of hematopoietic stem cells in zebrafish
 Bone Marrow and Stem Cell Transplants for the Family by Mission Positive Films
Bone Marrow and Stem Cell Transplants for the Family by Mission Positive Films
 Does donating peripheral blood stem cells (PBSC) impact a donor’s ability to have children?
Does donating peripheral blood stem cells (PBSC) impact a donor’s ability to have children?
 Hematopoietic Cell Transplantation (HCT) | CloudHospital TV
Hematopoietic Cell Transplantation (HCT) | CloudHospital TV